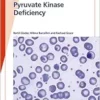
Fast Facts: Pyruvate Kinase Deficiency (EPUB) Fast Facts: Pyruvate Kinase Deficiency (EPUB)

By M. Pinamonti, F. Zanconati, P. Vielh Breast cytopathology is a field characterized by practicality and diagnostic efficacy. This book focuses mainly on morphology, with helpful hints for recognizing benign lesions and the main features of malignancy. It reviews specific features of various lesions and the consequences of the diagnosis for the management of the patient. Each chapter contains high-quality cytology images accompanying the descriptions, including comparison images to distinguish the most important morphological features and to help in the differential diagnosis. Fine needle aspiration cytology (FNAC) sampling and preparation technique, fixation, staining, and principles of its interpretation are covered. Immunocytochemistry and ancillary techniques are outlined, as well as the main clinical and radiological features of breast lesions, and the cytological diagnostics of axillary lymph nodes. This publication will be of great use to medical practitioners in their first approach to breast cytopathology, as well as to pathologists and cytotechnicians with little to moderate experience in the field.
Product Details
ASIN : 3318061409
Publisher : S Karger Ag; 1st edition (December 14, 2017)
Language : English
Hardcover : 120 pages
ISBN-10 : 9783318061406
ISBN-13 : 978-3318061406

Reviews
There are no reviews yet.